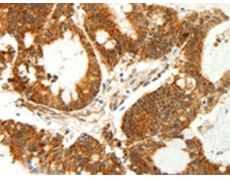
一抗

中文名稱: 兔抗COX7B多克隆抗體
|
Background: |
Cytochrome c oxidase (COX), the terminal component of the mitochondrial respiratory chain, catalyzes the electron transfer from reduced cytochrome c to oxygen. This component is a heteromeric complex consisting of 3 catalytic subunits encoded by mitochondrial genes and multiple structural subunits encoded by nuclear genes. The mitochondrially-encoded subunits function in electron transfer, and the nuclear-encoded subunits may function in the regulation and assembly of the complex. This nuclear gene encodes subunit VIIb, which is highly similar to bovine COX VIIb protein and is found in all tissues. This gene may have several pseudogenes on chromosomes 1, 2, 20 and 22. |
|
Applications: |
ELISA, WB, IHC |
|
Name of antibody: |
COX7B |
|
Immunogen: |
Fusion protein of human COX7B |
|
Full name: |
Cytochrome c oxidase subunit VIIb |
|
Synonyms: |
APLCC |
|
SwissProt: |
P24311 |
|
ELISA Recommended dilution: |
2000-5000 |
|
IHC positive control: |
Human colon cancer |
|
IHC Recommend dilution: |
50-200 |
|
WB Predicted band size: |
9 kDa |
|
WB Positive control: |
293T cells |
|
WB Recommended dilution: |
500-2000 |


 購物車
購物車 幫助
幫助
 021-54845833/15800441009
021-54845833/15800441009